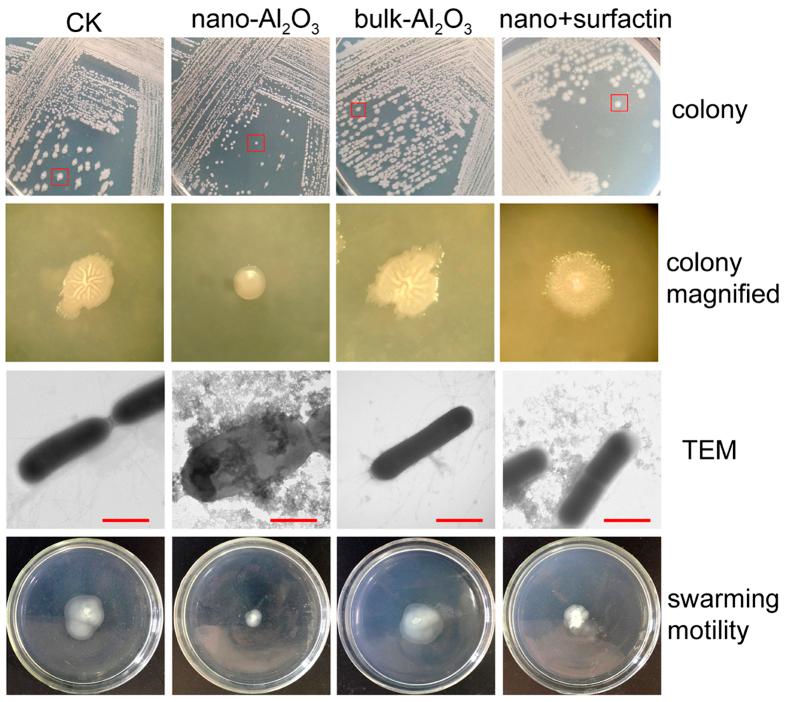
https://cdn.ncbi.nlm.nih.gov/pmc/blobs/ddee/4954987/801823ff8483/srep29953-f3.jpg

生理和转录组学分析揭示了海洋枯草芽孢杆菌 C01 适应氧化铝纳米颗粒的机制见解。
Physiological and transcriptomic analyses reveal mechanistic insight into the adaption of marine Bacillus subtilis C01 to alumina nanoparticles.
机构信息
State Key Laboratory of Microbial Technology, Shandong University, Jinan 250100, PR China.
College of Marine Science, Shandong University (Weihai), Weihai 264209, PR China.
出版信息
Sci Rep. 2016 Jul 21;6:29953. doi: 10.1038/srep29953.
An increasing number of studies have investigated the effects of nanoparticles (NPs) on microbial systems; however, few existing reports have focused on the defense mechanisms of bacteria against NPs. Whether secondary metabolism biosynthesis is a response to NP stress and contributes to the adaption of bacteria to NPs is unclear. Here, a significant induction in the surfactin production and biofilm formation were detected by adding Al2O3 NPs to the B. subtilis fermentation broth. Physiological analysis showed that Al2O3 NP stress could also affect the cell and colony morphogenesis and inhibit the motility and sporulation. Exogenously adding commercial surfactin restored the swarming motility. Additionally, a suite of toxicity assays analyzing membrane damage, cellular ROS generation, electron transport activity and membrane potential was used to determine the molecular mechanisms of toxicity of Al2O3 NPs. Furthermore, whole transcriptomic analysis was used to elucidate the mechanisms of B. subtilis adaption to Al2O3 NPs. These results revealed several mechanisms by which marine B. subtilis C01 adapt to Al2O3 NPs. Additionally, this study broadens the applications of nanomaterials and describes the important effects on secondary metabolism and multicellularity regulation by using Al2O3 NPs or other nano-products.
越来越多的研究调查了纳米颗粒 (NPs) 对微生物系统的影响;然而,现有的少数报告集中在细菌对 NPs 的防御机制上。是否次级代谢物生物合成是对 NP 胁迫的一种反应,并有助于细菌对 NPs 的适应尚不清楚。在这里,通过向枯草芽孢杆菌发酵液中添加 Al2O3 NPs,检测到表面活性剂产量和生物膜形成的显著诱导。生理分析表明,Al2O3 NP 胁迫还会影响细胞和菌落形态发生,并抑制运动性和孢子形成。添加商业表面活性剂可恢复群集运动性。此外,还使用了一系列毒性分析,包括膜损伤、细胞 ROS 生成、电子传递活性和膜电位,以确定 Al2O3 NPs 的毒性分子机制。此外,还进行了全转录组分析,以阐明枯草芽孢杆菌适应 Al2O3 NPs 的机制。这些结果揭示了海洋枯草芽孢杆菌 C01 适应 Al2O3 NPs 的几种机制。此外,本研究拓宽了纳米材料的应用,并描述了使用 Al2O3 NPs 或其他纳米产品对次级代谢物和多细胞性调节的重要影响。